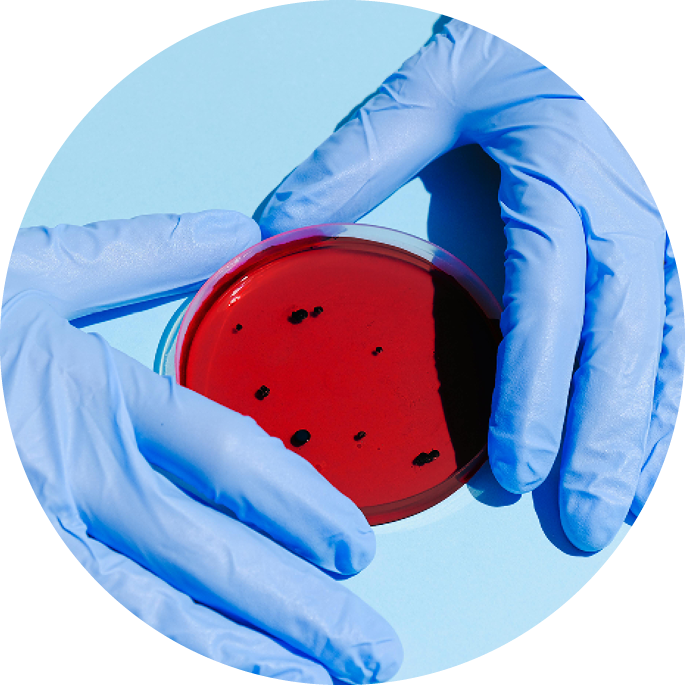
Zwei behandschuhte Hände halten eine Petrischale mit rotem Nährmedium und schwarzen Punkten auf hellblauem Hintergrund.

MSH Research, Development &
Innovation gGmbH
Bei der MSH Research, Development & Innovation gGmbH handelt es sich um eine in gemeinnütziger Rechtsform geführte Forschungseinrichtung, an der laut ihrem Satzungszweck Wissenschaftler:innen der MSH Medical School Hamburg im nichtwirtschaftlichen Bereich liegende, wissenschaftliche Forschungsvorhaben insbesondere in den Bereichen der Medizin, Psychologie/ Psychiatrie/ Psychotherapie, Neurowissenschaften, Umwelt/ Sozialer Raum und Nachhaltigkeit, Gesundheitswissenschaften und Arts Health and Social Sciences durchführen können.
Als gGmbH unterliegt die MSH-RDI den steuer- und handelsrechtlichen Vorschriften des HGB. Wissenschaftler:innen der MSH nutzen die MSH-RDI und deren Infrastruktur zur Durchführung von mit Drittmitteln geförderten sowie nicht-geförderten Forschungsprojekten.

Forschungsvorhaben
Auswahl aktueller Forschungsvorhaben
Forschungsinfrastruktur
Forschungslabore zur Umsetzung wissenschaftlicher Projekte

Sicherung guter wissenschaftlicher Praxis
MSH RDI Leitlinien
